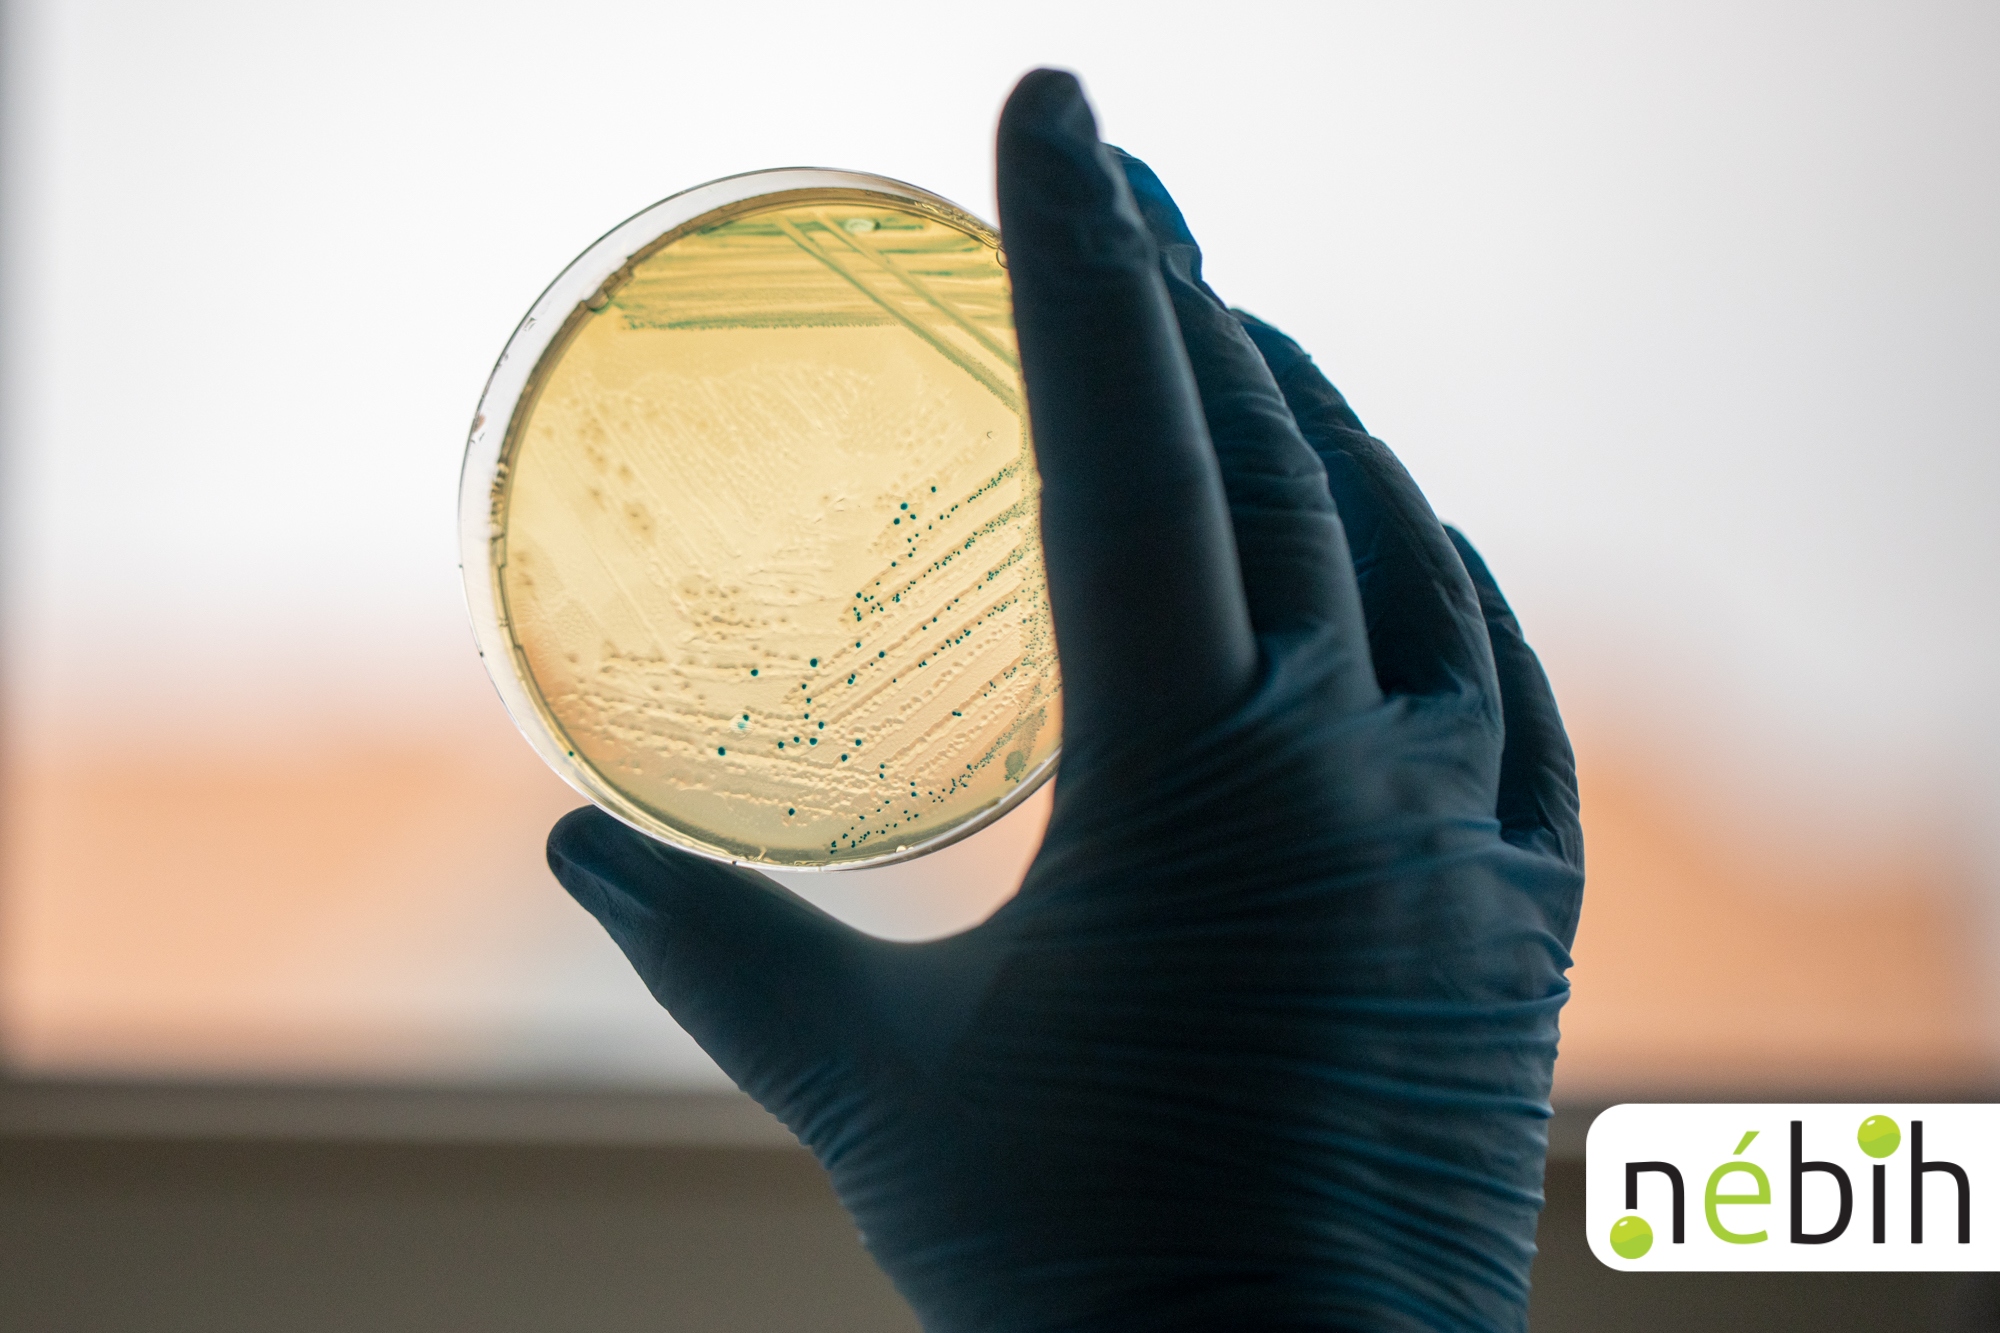
A képen egy fekete gumikesztyűs kéz tart egy petri csészét.

A felelős lótartás része, hogy odafigyelünk az állatok terhelés utáni regenerációjára és a számukra megfelelő termékekkel kezeljük őket. A Szupermenta tesztjében ezúttal 16, a lovak sportteljesítményét támogató, mentoltartalmú terméket vettünk górcső alá. Csapjunk is a lovak közé! Lássuk a teszt részleteit és eredményeit!
Sokszínű kínálat
Sokféle gyógyhatású termék és ápolószer elérhető lovak számára, melyek többféle formában kaphatóak és különböző javallataik vannak. Az állatgyógyászati termékek az alábbi kategóriákba tartozhatnak:
- állatgyógyászati készítmények (gyógyszerek, illetve immunológiai készítmények)
- állatgyógyászati biocid termékek
- állatgyógyászatban használt egyéb gyógyhatású készítmények (gyógyhatású termékek, ápolószerek, segédanyagok)
A Szupermenta tesztjébe a lovak sportteljesítményét támogató, mentolt tartalmazó gyógyhatású termékek és ápolószerek kerültek be. A 16 termék között volt gél, zselé és emulzió is. Ezeket általában intenzív erőkifejtés, versenyhelyzet után érdemes használni, mivel jellemzően hűsítik, felfrissítik az ínakat, ízületeket, izmokat, bizonyos termékek a regenerálódást segítik elő, de olyanok is vannak, melyek ízületgyulladások, szöveti duzzanatok, heveny gyulladások kiegészítő kezelésére alkalmasak. Kiszerelésüket tekintve a termékek 200 és 500 ml, valamint 180 és 2000 g között mozogtak. Két terméket külföldről szereztünk be online rendeléssel. Lássuk a teszt részleteit és az eredményeket!
Laboratóriumi vizsgálatok
- mikrobiológiai vizsgálatok,
- mentoltartalom,
- pH
Mikrobiológiai vizsgálatok
A kapott mérési eredmények alapján a szakértők megfelelőnek értékelték a termékeket.
Mentoltartalom – a hűsítő frissesség
A tesztelt termékek mindegyike mentollal készült, ezért a laboratóriumban megmérték, hogy mekkora mennyiségben tartalmazzák ezt az összetevőt. Az eredmények alapján elmondható, hogy a mentoltartalmuk rendkívül széles skálán, 84 és 18.700 mg/kg között mozgott. Jogszabály által előírt határérték ugyan nincs a mentoltartalomra, de a nyilvántartásba vétel során benyújtott minőségi bizonyítványban szereplő értékhez igazodnia kell a terméknek.
Szakembereink megvizsgálták a minták mentoltartalmát, és összehasonlították a rendelkezésre álló dokumentációkkal. Jó hír, hogy egyetlen esetben sem volt jelentősnek tekinthető eltérés.
pH-tartalom – a bőrbarát termékek fokmérője
Mivel a vizsgált termékek külsőleg alkalmazandók, vagyis közvetlenül a ló bőrére kerülnek, különösen fontos, hogy bőrbarát kémhatással rendelkezzenek. A lovak bőre közel semleges kémhatású, 5,5 és 7,5 közötti pH értékű. A túlságosan savas vagy lúgos készítmények felboríthatják a bőr természetes egyensúlyát, ami irritációhoz vagy akár a bőr sérüléséhez is vezethet.
A teszt során a Nébih laboratóriumában megmérték a termékek pH-tartalmát, amelyek 5,2 és 7,3 érték közöttiek voltak, és ellenőrizték a hibahatár figyelembevételével, hogy megfelelnek-e a benyújtott dokumentációkban szereplő pH-értékeknek.
Jó hír, hogy az eredményeket a legtöbb esetben rendben találták. Ahol volt jelentősebb eltérés, ott a szakemberek értesítették a forgalmazót a hiba javítására. Szerencsére a különbség nem jelent állategészségügyi kockázatot.
Nagyító alatt a csomagolás
A 128/2009 rendelet 13. sz. melléklete alapján a készítmények külső csomagolásán kötelező feltüntetni többek között a termék nevét, az összetevőit mennyiség szerinti felsorolásban, a célállatfajt, az adagolást, az alkalmazás módját, a lejárati időt, valamint a tárolási előírásokat. A forgalomba hozatali engedély jogosultjának neve és címe, valamint a gyártási és a nyilvántartási szám is kötelezően feltüntetendő elem a csomagoláson. Továbbá a „Kizárólag állategészségügyi vagy állatápolási célra!” feliratnak is szükséges szerepelnie.
A hatósági szakemberek alaposan szemügyre vették a csomagolásokat és számos hiányosságot tapasztaltak az ellenőrzés során.
Három termék nem felelt meg a követelményeknek: az ellenőrzés idején engedély nélkül voltak forgalomban.
Az érintetett vállalkozásokkal szemben hatósági eljárás indult jogszabályellenes forgalmazás miatt. A forgalmazók időközben pótolták a hiányosságokat, illetve megszüntették a jogszabályellenes forgalmazást.
A termékek több mint felénél hiányzott a nyilvántartási szám, valamint jellemző hiba volt, hogy a lejárati időt nem megfelelően tüntették fel és hiányoztak a jelölésről a termék használatára vonatkozó figyelmeztetések. A tesztelt termékek mintegy felén nem szerepelt a „Kizárólag állategészségügyi vagy állatápolási célra!” felirat, néhány esetben pedig a célállatfaj vagy a tárolási előírások feltüntetését hiányolták az ellenőrök. Előfordult az is, hogy bár a kötelező adatok többsége szerepelt a csomagoláson, azok nem egyeztek az engedélyezett termékismertetővel.
A Nébih munkatársai figyelmeztették az érintett gyártókat a feltárt hibák kijavítására. A bírságok együttes összege mintegy 120.000 forint volt.
A külföldi internetes áruházban vásárolt termékek rendszerint nem rendelkeznek Nébih engedélyszámmal és magyar nyelvű termékirodalommal sem. Bár a termékek használata nem minden esetben ártalmas, tudatos vásárlóként tisztában kell lennünk azzal, hogy a termékek fokozott kockázattal járnak. Ez abból adódik, hogy a magyar hatóság nyilvántartásában ezek a termékek nem szerepelnek, így egy esetleges minőségi hiba vagy nem kívánatos hatás jelentkezése esetén nem nyomonkövethetők.
A Nébih nem javasolja állatgyógyászati termékek vásárlását külföldi internetes oldalakról!
Szupermenta-tipp
- Felelős állattartóként állatgyógyászati termékeket azok forgalmazására jogosult forgalmazótól vásároljunk!
- Ha idegen nyelvű vagy feltűnően magyartalan szöveggel találkozunk, érdemes gyanakodni, és felkeresni a Nébih honlapját, ahol megtalálható az összes Magyarországon forgalmazható termék listája: https://atiportal.nebih.gov.hu/
- Nagyon fontos, hogy ne csak magunk, de az állataink számára is kizárólag engedéllyel rendelkező, ellenőrzött termékeket vásároljunk! Így állatgyógyászati termékek esetén érdemes keresni nyilvántartásbavételi azonosítót (pl. 1448/1/2019 NÉBIH ÁTI vagy 290/1/2012 MgSzH ÁTI) a termékek csomagolásán.

Kapcsolódó tartalmaink
ÖSSZESÍTETT EREDMÉNYEK
A részletes eredményeket
bemutató táblázatot
itt letöltheti!
KEDVELTSÉGI VIZSGÁLAT
Itt megtudhatja, milyen
szempontok szerint pontozták
a termékeket.




